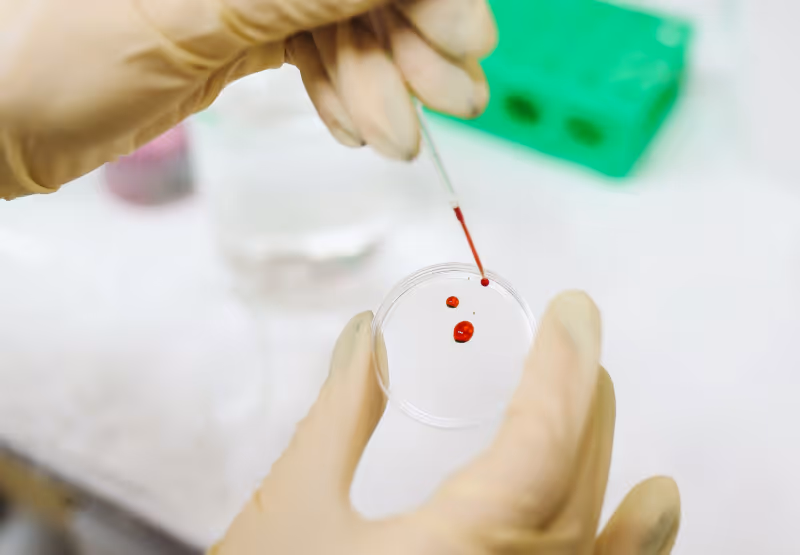
Petri dish with blood in it

Can Iron Deficiency Cause High Blood Sugar? Anemia and Glucose
Key Takeaways
- Anemia and glucose: While anemia does not typically cause diabetes, it can interfere with how red blood cells process glucose, potentially leading to inaccurate HbA1c results and glucose monitor readings.
- Iron deficiency and blood sugar: Low iron levels can impact metabolic health by influencing insulin sensitivity and red blood cell lifespan, which may cause a false elevation in certain diagnostic tests.
- Anemia and A1c levels: Iron deficiency anemia can falsely elevate HbA1c results because slower red blood cell turnover allows more time for hemoglobin to become glycated, even if actual glucose levels remain stable.
- Anemia and glucose: While anemia does not typically cause diabetes, it can interfere with how red blood cells process glucose, potentially leading to inaccurate HbA1c results and glucose monitor readings.
- Iron deficiency and blood sugar: Low iron levels can impact metabolic health by influencing insulin sensitivity and red blood cell lifespan, which may cause a false elevation in certain diagnostic tests.
- Anemia and A1c levels: Iron deficiency anemia can falsely elevate HbA1c results because slower red blood cell turnover allows more time for hemoglobin to become glycated, even if actual glucose levels remain stable.
Did you know that people with diabetes have a higher chance of developing anemia? It makes sense that the two might be connected as both conditions can impact red blood cell production.Â
But what other factors cause blood sugar and anemia to be related? And do abnormal glucose levels impact iron levels, or is it the other way around? Read on to learn more about the causes and symptoms of anemia and how this condition may affect your blood sugar levels.
What is Anemia?

Anemia is a common condition that affects about one-fourth of the global population. It occurs when someone produces fewer red blood cells than usual.
Hemoglobin, a protein in red blood cells, carries oxygen to the body's organs and tissues and carbon dioxide from them to the lungs.
A person with anemia doesn't have enough hemoglobin in the blood, and your organs and tissues don't get enough oxygen. This lack of oxygen can cause fatigue, weakness, and other serious symptoms.
Symptoms of AnemiaÂ
Early on, anemia symptoms can be so mild that they are hard to notice, but they can become more apparent as anemia worsens. If you experience any common signs and symptoms of anemia listed below, you may want to consult your doctor or healthcare provider.

‍

Causes of AnemiaÂ
According to researchers, anemia is not a diagnosis but a sign of another underlying condition. It has multiple causes that can be grouped into three categories:
- Conditions that cause a decrease in the production of red blood cells
- Conditions that cause increased destruction of red blood cells
- Conditions that cause a loss of blood, particularly when you lose blood quicker than your body can produce new red blood cells
Within these umbrella categories, many potential conditions can cause anemia. Some examples of conditions that can cause anemia include:
- Blood loss (from acute trauma or internal bleeding)
- Deficiencies in nutrients (that aid in red blood cell production, like iron, vitamin B12, and folate)
- General malnutrition
- Chronic diseases (including liver disease and kidney disease, cancer, or chronic inflammation)
- Genetic illnesses
- Infectious diseases like malaria
- Some prescription drugs or treatments (including some diuretics, chemotherapy, hypoglycemia drugs like Metformin, antimicrobials, anticonvulsants, and antiretroviral drugs)
- Chemical exposures (like lead poisoning)
- Autoimmune diseases
- Bone marrow diseases
- Hypothyroidism
- PregnancyÂ
- Bacteria infections
Can Anemia Affect Blood Sugar?

Yes, anemia could possibly affect blood sugar in various ways. However, the connection between glucose and anemia is complex and not yet fully understood. And although diabetes may not cause anemia directly, it can contribute to its development in several ways.
Iron deficiency anemia (a specific type of anemia) is common in people who have type 2 diabetes, especially those with diabetic nephropathy (a complication of diabetes that damages the kidneys). Still, the effect of iron deficiency on glucose metabolism isn't clear.
Studies indicate that high glucose levels in blood vessels can cause decreased iron absorption, leading to iron deficiency anemia and iron overload. Gastrointestinal bleeding and kidney damage are other common diabetes complications that can lead to anemia.
Does Low Iron Cause High Blood Sugar?
What if you have low iron levels or anemia and no history of blood sugar problems? Can this type of anemia still affect your blood sugar?
Some research suggests that iron deficiency anemia may indeed impact blood sugar. Animal studies have found that iron deficiency can cause changes in glucose metabolism, fat metabolism, and insulin signaling. Even slight iron deficiency led to significant changes in glucose and insulin regulation.
Other animal studies have shown possible links between severe iron deficiency and glycemic response. Elevated serum glucose and lipid levels were more common in severely iron-deficient rodents. The reduction in hemoglobin appears to be highly correlated with the severity of hyperglycemia and hyperlipidemia, though some studies show conflicting results.
One human trial evaluated the effects of correction of iron deficiency anemia on insulin resistance in 54 non-diabetic premenopausal women. Significant decreases were found in fasting insulin levels after correction of anemia in women under 40 with a normal body mass index. Following treatment, fasting insulin levels were positively correlated with hemoglobin levels.
Although anemia doesn’t cause diabetes, staying on top of it can help you prevent conditions like this (and keep you healthier overall!). Non-diabetic glucose monitoring can come in handy here to help you keep an eye on your blood sugar levels and help you make informed choices for your health.
The Link Between A1C Levels and Anemia
A 2014 study of 120 people with diabetes and iron deficiency anemia found a positive correlation between iron deficiency and high HbA1c levels. HbA1c levels measure how much glucose has attached itself to the hemoglobin in your blood. Elevated HbA1c levels can indicate a high amount of sugar in the blood over a 90-day period.
Because iron-deficiency anemia has been shown to raise HbA1c levels, it may lead to a false diagnosis of diabetes. More research is needed to determine why anemia can raise HbA1c levels and what kinds of anemia can impact the reliability of HbA1c tests.
While research is ongoing, the authors of one study recommend that doctors recognize that different results in glucose and HbA1c levels could be a sign of anemia
Nutrition Support for Anemia

Nutrition interventions might help you manage anemia, though nutrition needs may depend on the cause of your anemia. Taking steps such as increasing your iron intake or vitamin B12 intake may be a good idea, but you have to work with a professional to find what works best for your unique body.
Not all forms of anemia should be considered the same, as they may not require the same approach to treatment or nutrition support. As we mentioned earlier, some people may have anemia due to vitamin B12 or iron deficiencies, while others may have anemia caused by genetic factors or other underlying conditions.
If your doctor has diagnosed you with anemia, it may be a good idea to support your treatment with 1:1 nutrition support from a qualified professional, like a registered dietitian or nutritionist.
How is Anemia Diagnosed?
Because there are so many potential causes of anemia, this condition should be diagnosed by a medical professional. If you think you may be experiencing symptoms of anemia, visit a qualified healthcare provider. They'll usually take several blood samples and order tests to check for iron deficiency, vitamin B12 or folate deficiency, or other possible causes of anemia. Here’s what to expect:
Some Common Tests Used to Diagnose Anemia
Your doctor may diagnose anemia based on your medical and family history, a physical exam, or lab test results. These tests include blood tests, bone marrow tests, or other diagnostic tests.
Blood Tests
A complete blood count (CBC) test for anemia may determine your:
- Red blood cell and hemoglobin count. If your blood cell count levels are lower than normal, this may indicate anemia.
- Hematocrit levels measure the space red blood cells occupy in the blood. Too low a level may be a sign of anemia.
- Mean corpuscular volume (MCV) levels measure the average size of your red blood cells. In iron-deficiency anemia, red blood cells are usually smaller than normal. In macrocytic anemia (caused by vitamin B12 or folate deficiency), red blood cells are usually larger than normal.
Bone Marrow Tests
A bone marrow test for anemia may be used to determine whether your bone marrow is making normal amounts of blood cells. A bone marrow test will include:
- Aspiration, which involves a small amount of bone marrow fluid being collected through a needle
- Biopsy, which involves a small amount of bone marrow tissue being collected through a larger needle. The bone marrow samples will be studied in a laboratory.
Other Tests for Anemia
Other diagnostic tests for anemia include:
- Colonoscopy, which looks for bleeding or other problems like tumors in the colon.
- Endoscopy is a test that looks for bleeding and abnormal growth in the esophagus, stomach, and the first part of the small intestine.
- Genetic tests can look for changes in the genes that control how your body makes red blood cells.
- Urine tests measure whether your kidneys are functioning properly and whether there is bleeding in your urinary tract.
Types of Anemia

Did you know there were different types of anemia? That’s right, anemia can have multiple causes and types. Here are a few you should know about:
Iron Deficiency Anemia
Iron deficiency anemia is a common type of anemia caused by insufficient iron intake or absorption. When your blood doesn't contain enough iron, your body can't produce enough hemoglobin. This can cause cold hands, fatigue, and shortness of breath in mild cases and more serious health conditions in severe cases, such as irregular heartbeat and heart failure. It's often treated with iron supplements.
Vitamin Deficiency Anemia
Lower-than-usual levels of vitamin B12 and folate can cause vitamin deficiency anemia, also known as macrocytic anemia. Without these nutrients, your body produces red blood cells that are too large and don't work properly, which can reduce their ability to carry oxygen. It can be treated with foods rich in B12, folate, and vitamin dietary supplements.
Aplastic Anemia
Aplastic anemia is rare but quite serious. It occurs when the body stops producing enough new red and white blood cells. It can cause fatigue and make one more prone to infections and uncontrolled bleeding. Treatment for aplastic anemia may include medication, blood transfusions, or a bone marrow transplant.
Sickle Cell Anemia
Sickle cell anemia, also called sickle cell disease, is an inherited genetic disorder that affects the shape of red blood cells. Red blood cells are usually round and flexible, allowing them to move easily through the body.
If you have sickle cell anemia, your blood cells are sickle or crescent-shaped, making them rigid and sticky and leading to slowed or blocked blood flow. There's no cure for sickle cell anemia, but there are treatments to prevent complications.
Thalassemia

Thalassemia is an inherited genetic disorder that causes the body to have less hemoglobin than normal, which can lead to anemia. Mild forms require no treatment, but severe forms may require blood cell transfusions.
Hemolytic Anemia
This type of anemia occurs when red blood cells are destroyed faster than they can be made. Inherited conditions, autoimmune disorders, infections, or medications for certain medical conditions can cause hemolytic anemia. Treatment may include addressing the underlying cause, blood transfusions, and medications to suppress the immune system. In some cases, surgery may be necessary to remove the spleen, which breaks down old red blood cells.
Refractory Anemia
Refractory anemia is caused by the bone marrow not producing enough healthy, functioning red blood cells. It's a type of Myelodysplastic Syndrome (MDS), a group of stem cell disorders in which the bone marrow fails to make enough healthy blood cells.Â
This can lead to anemia and other complications like infections, rheumatoid arthritis, and chronic conditions such as ulcerative colitis, metabolic syndrome, inflammatory bowel disease, gastrointestinal tract bleeding, and heart failure.Â
Treatment may include medications to stimulate the production of new blood cells, blood transfusions, and, in some cases, bone marrow transplants.
There’s also pernicious anemia, an autoimmune condition that leads to decreased B12 absorption in the stomach. This is more common among people with Type 1 Diabetes. Remember, it’s best to work with a health professional to address any potential symptoms and deficiencies.
‍
Find the right Nutrisense programto turn insight into progress.
Engage with Your Blood Glucose Levels with Nutrisense
Anemia may impact your blood glucose levels and HbA1c results, but it doesn't have to stop you from living a healthy and fulfilling life.Â
Whether you’re iron-deficient, want to prevent other chronic conditions, or just curious, Nutrisense can help! When you sign up, you get access to a team of accredited dietitians and nutritionists who are all experts in blood sugar management and personalized nutrition.Â
You can choose to work with them 1:1 through various support options and dive deeper as you monitor your blood glucose fluctuations with a continuous glucose monitor (CGM) to learn how your body responds to different foods and lifestyle choices. By learning more about your body's unique needs, you will have everything you need to take control of your health.Â
Curious about how the Nutrisense program can help you on your journey? Take our quiz to find the right fit for your needs.
Frequently Asked Questions
Can iron deficiency cause high blood sugar?
Iron deficiency can cause a false elevation in certain blood sugar tests, such as the HbA1c, by extending the lifespan of red blood cells. This allows more glucose to bind to hemoglobin over time, potentially leading to higher test results even if your daily glucose variability remains within a healthy range.
Can anemia cause low blood sugar?
Anemia can occasionally be associated with low blood sugar symptoms like fatigue and dizziness, though it is not a direct cause of hypoglycemia. Both conditions can lead to similar metabolic stress, making it important to monitor your individual glucose response to differentiate between nutrient deficiencies and glucose-related energy drops.
Can diabetes cause anemia?
Yes, people with diabetes have an increased risk of developing anemia, often due to chronic kidney disease or inflammation that affects red blood cell production. Managing both conditions requires a personalized approach to nutrition and metabolic optimization, often guided by a Registered Dietitian to ensure stable energy levels.
Go Beyond Glucose Data with Nutrisense
Your glucose can significantly impact how your body feels and functions. That’s why stable levels are an important factor in supporting overall wellbeing. But viewing glucose isn't enough. Nutrisense, you’ll be able to learn how to use your body's data to make informed lifestyle choices that support healthy living.
One-to-one coaching
Sign up to access insurance-covered video calls to work with a glucose expert: a personal registered dietitian or certified nutritionist who will help tailor your lifestyle and diet to your goals.
Monitor and measure what matters
With the Nutrisense CGMÂ Program, you can monitor your glucose with health tech like glucose biosensors and continuous glucose monitor (CGM)s, and analyze the trends over time with the Nutrisense App. This will help you make the most informed choices about the foods you consume and their impact on your health.
Find your best fit
Ready to take the first step? Start with our quiz to find the right Nutrisense program to help you take control.

Liz has a Master of Science degree in Clinical Nutrition and Integrative Health and is a board-certified nutrition specialist (CNS) and a licensed dietitian nutritionist (LDN). As a nutritionist, Liz has educated and counseled 100s of clients in areas such as weight loss, hormonal imbalances, and gastrointestinal diseases.

